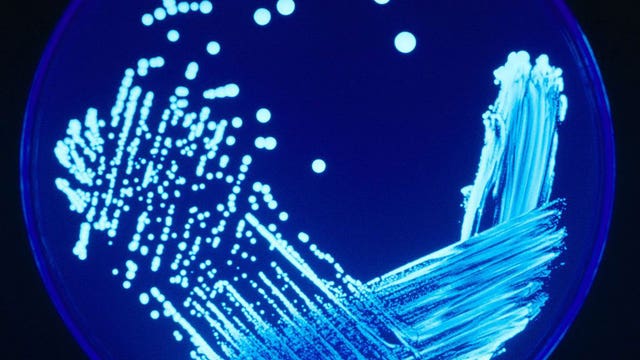
Legionnaire's disease; positive case identified in West Allis

West Allis Downtown Say Cheese! Food Crawl
Brian Kramp visits Downtown West Allis, where they're getting ready for tonight’s Say Cheese! Food Crawl.
Brian Kramp visits Downtown West Allis, where they're getting ready for tonight’s Say Cheese! Food Crawl.
Wisconsin State Fair Sporkies, Drinkies winners announced for 2024
The Wisconsin State Fair on Tuesday announced the winners of the 2024 Sporkies & Drinkies.
The Wisconsin State Fair on Tuesday announced the winners of the 2024 Sporkies & Drinkies.
Wisconsin State Fair food; Saz's in thick of busy catering season
The Wisconsin State Fair is one of the area's most popular summer events. Saz's Hospitality Group has served almost all of them.
The Wisconsin State Fair is one of the area's most popular summer events. Saz's Hospitality Group has served almost all of them.
Wisconsin State Fair amusement ride inspections ahead of opening day
Crews are making sure everything is in top shape leading up to the Wisconsin State Fair.
Crews are making sure everything is in top shape leading up to the Wisconsin State Fair.
Wisconsin State Fair: Get set to devour cream puffs
The 2024 edition of the Wisconsin State Fair is almost here – and that means it's cream puff season.
The 2024 edition of the Wisconsin State Fair is almost here – and that means it's cream puff season.
WI State Fair free tickets; UScellular giveaway, what you need to know
UScellular announced on Wednesday, July 24 it is celebrating the 173rd Wisconsin State Fair with a giveaway of 3,500 tickets at stores across southeast Wisconsin on Thursday.
UScellular announced on Wednesday, July 24 it is celebrating the 173rd Wisconsin State Fair with a giveaway of 3,500 tickets at stores across southeast Wisconsin on Thursday.
Silver Alert canceled: Missing West Allis man found safe
A Silver Alert has been canceled for 61-year-old Charles Stephan of West Allis. He has been found safe.
A Silver Alert has been canceled for 61-year-old Charles Stephan of West Allis. He has been found safe.
Global tech outage: West Allis family stuck in Mexico
A West Allis family is stuck in Mexico following the technology outage that began Friday morning, July 19.
A West Allis family is stuck in Mexico following the technology outage that began Friday morning, July 19.
Legionnaire's disease; positive case identified in West Allis
The Southwest Suburban Health Department has identified a positive case of Legionnaire's disease.
The Southwest Suburban Health Department has identified a positive case of Legionnaire's disease.
West Allis police chase; squad hit, stolen car's driver sought
A West Allis police squad was hit during a Thursday afternoon pursuit. The car involved had been stolen out of Milwaukee.
A West Allis police squad was hit during a Thursday afternoon pursuit. The car involved had been stolen out of Milwaukee.
Wisconsin State Fair: 100 new foods, beverages for 2024
Thursday, July 11 is National State Fair Food Day – and the Wisconsin State Fair is celebrating the 100 new food and beverage options available to all fair goers for 2024.
Thursday, July 11 is National State Fair Food Day – and the Wisconsin State Fair is celebrating the 100 new food and beverage options available to all fair goers for 2024.
West Allis police chase into Milwaukee; 2 in custody
Two people were taken into custody following a police pursuit that began in West Allis and ended in Milwaukee.
Two people were taken into custody following a police pursuit that began in West Allis and ended in Milwaukee.
Sheridan Park shooting, West Allis man charged
A West Allis man has been charged in a shooting that happened at Sheridan Park in Cudahy on Friday, June 28.
A West Allis man has been charged in a shooting that happened at Sheridan Park in Cudahy on Friday, June 28.
I-894 crash, Milwaukee County Sheriff squad vehicle involved
A Milwaukee County sheriff squad vehicle was involved in a crash on I894 in West Allis on Monday, July 1.
A Milwaukee County sheriff squad vehicle was involved in a crash on I894 in West Allis on Monday, July 1.
I-894 crash involving MCSO squad vehicle
A crash on I-894 involved multiple vehicles, including a Milwaukee County sheriff's squad. Traffic was backed up for several hours.
A crash on I-894 involved multiple vehicles, including a Milwaukee County sheriff's squad. Traffic was backed up for several hours.
Silver Alert: West Allis man reported missing found safe
UPDATE: Police say Sherman Williams has been found safe.
UPDATE: Police say Sherman Williams has been found safe.
Cream Puff 5K raises money for Wisconsin State Fair Park Foundation
The eighth annual Cream Puff 5K takes place at Wisconsin State Fair Park on Wednesday night, June 26.
The eighth annual Cream Puff 5K takes place at Wisconsin State Fair Park on Wednesday night, June 26.
Girls on the Run
At Liberty Heights Park outside of Horace Mann Elementary School in West Allis, this group of fearless girls are members of Girls on the Run.
At Liberty Heights Park outside of Horace Mann Elementary School in West Allis, this group of fearless girls are members of Girls on the Run.
Girls on the Run: Empowerment program for girls, 3rd thru 8th grade
At Liberty Heights Park outside of Horace Mann Elementary School in West Allis, this group of fearless girls are members of Girls on the Run.
At Liberty Heights Park outside of Horace Mann Elementary School in West Allis, this group of fearless girls are members of Girls on the Run.
Wisconsin State Fair Sporkies, Drinkies finalists announced for 2024
Wisconsin State Fair officials announced finalists for the 2024 Sporkies & Drinkies on Wednesday, June 12.
Wisconsin State Fair officials announced finalists for the 2024 Sporkies & Drinkies on Wednesday, June 12.